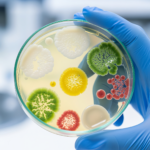
פתיחת צלחת פטרי בחלל החדר

סדרת דוגמי האוויר החדשניים TRIO.BAS (מבית Orum האיטלקית) מאפשרים בקלות ופשטות יכולות ניטור מדויקות בחדר הנקי, בקלות תפעולית , חיסכון בזמן.
מאת: צוות hylabs
חדרים נקיים נדרשים לבצע ארבעה סוגי דיגום, כאשר העיקרי מביניהם הינו דיגום אוויר אקטיבי על בסיס קבוע, על מנת לוודא ולהוכיח כי הם נקיים מחיידקים וזיהומים (Air Active Sampling). הרגולציה הנדרשת מחדרים נקיים מגדירה ניטור סביבתי בהתאם למשך הפעילות בחדר הנקי. ככלל, הרגולציה מגדירה פעולת ניטור של שתי אוכלוסיות מיקרואוגניזמים המבוצעות באמצעות צלחות פטרי: צלחת של ספירה כללית ובנוסף צלחת המתמקדת בשמרים ועובשים.
הדרך הבסיסית והותיקה לביצוע הבדיקה: פתיחת צלחות פטרי בחלל החדר
הדרך הבסיסית והותיקה לביצוע הבדיקה: פתיחת צלחות פטרי בחלל החדר (Settling plate Passive Air Sampling ( . עד ל 4 שעות זמן חשיפה.
כיום יש שיטה נוספת לבחינת העומס המיקרוביאלי באמצעות דוגמי אוויר המספקים שיטה אקטיבית, מהירה ויעילה לאיתור מזהמים בחדרים נקיים.
ניתן להפעיל דוגם אוויר בחדר נקי באופן רציף או לפרק זמן מוגדר .
בדיקת חדרים נקיים – דגשים חשובים

דוגם אוויר שואב את האוויר ופולט אותו על צלחת הפטרי הממוקמת בראש הדוגם באופן אקטיבי.
איך מבוצע תהליך הדיגום?
מניחים צלחת פטרי בראש הדוגם, על גביה מבריגים ראש נירוסטה מעוקר ומפעילים את המכשיר לדיגום בנפח שנקבע מראש, בהתאם לסיווג ((Class / Grade . ניתן גם לעשות שימוש בדוגם דו-ראשי על מנת ליעל זמני עבודה כך שהדוגם ידגום באופן סימולטני: ניתן לשים שני מצעים לקבלת ספירה כללית TSA וספירה של שמרים ועובשים SDA .
הרגולציה החדשה בתחום Air Sampling, אותה פרסם ארגון ה -GMP מחייבת דיגום מתמשך, שמשמעותו שהניטור מבוצע לאורך כל זמן העבודה במנדף. דוגמי אוויר רב ראשיים מספקים מענה הולם, בכך שהם מאפשרים לנטר לסירוגין.
יתרונות דוגם אוויר מבית ORUM
למכשיר הTRIO BAS מבית ORUM יתרונות רבים אשר הופכים אותו ל פתרון חדשני , מקצועי ונגיש המאפשר חיסכון בזמן, מוניעת טעויות תוך עמידה מלאה בתקני הרגולציה המחמירים ביותר.
היתרון הראשון הוא המחיר: הדוגם החדשני של TRIO.BAS (מבית Orum האיטלקית) המצויד בטכנולוגיה המעודכנת ביותר ונוחות שימוש מרבית הוא זול משמעותית ביחס למתחריו ומאפשר לכל מעבדה לשדרג את יכולות הניטור שלה לרמה הגבוהה ביותר הנדרשת.
מהירות דיגום גבוהה של 200 ליטר בדקה, המאפשרת קיצור משמעותי של זמני הדיגום ויעול עבודת הטכנאים בחדר.
דוגמי האוויר של TRIO.BAS עומדים ברגולציה הנדרשת CFR Part 11 – (למעט דגם Mini)המגדירה את הצורך בתיעוד שאינו ניתן למחיקה ושינוי (Data Integrity) בנוגע לנתוני ביצוע הדיגום. העמידה ברגולציה זו נעשית באמצעות תוכנה מיוחדת המאפשרת שמירת כל נתוני הניטור המועברים מהמכשיר. העברת הנתונים מתבצעת באחת בשתי דרכים: באמצעות כבל תקשורת המחובר למחשב או באמצעות בלוטות'. טעינת המכשיר נעשית באמצעות הכבל או באמצעות מעמד ייעודי המאפשר טעינה.

דוגם אוויר TRIO.BAS דו ראשי: טכנולוגיה מעודכנת, נוחות שימוש מרבית ומחיר זול משמעותית מהמתחרים.
יתרון נוסף של דוגם אוויר מדגם TRIO BAS הוא בכך ששירות התיקונים והכיול נעשה ע"י מח' השירות של Hylabs שהוסמכה לכך על ידי היצרן. הדוגם מגיע מראש מכויל לתקופה של שנה. בתום השנה הראשונה ניתן לבצע כיול על ידי מחלקת השירות, ולקבל לתקופה זו, מכשיר דיגום חלופי על מנת לשמר את שגרת הניטורים.

ראש הדוגם וכיסוי הראש עשויים פלדת אל חלד ועמידים לעיקור באוטוקלאב
יתרונות נוספים גלומים בחומרים מהם בנויים דוגמי האוויר מסדרה זו. ראש הדוגם וכיסוי הראש עשויים פלדת אל חלד ועמידים לעיקור באוטוקלאב (ניתן להזמין גם ראשים חד פעמיים סטריליים).
המכשיר עצמו מצופה בחומר אנטי-בקטריאלי, כאשר ניתן לחטא את כל חלקי המכשיר החיצוניים בעזרת מגוון חומרי ניקיון.
הדוגם מעוצב באופן ארגונומי וקל משקל ביחס למכשירי דיגום אחרים הנמכרים בשוק, דבר המהווה יתרון משמעותי בשימוש השוטף ומקל על הפעלתו בידי הטכנאים בחדר הנקי. הדוגם מגיע עם מזוודת נשיאה קשיחה, השומרת על המכשיר לאורך זמן ומאפשרת לנייד אותו בבטחה .
לדוגם סוללה פנימית המספקת הספק דיגום של 30 אלף ליטר (כשעתיים וחצי).
איך משתמשים בדוגם האוויר?
השימוש בדוגם האוויר הנו פשוט. לאחר הוצאת הדוגם מהמזוודה הקשיחה יש להציב אותו במקום בו נרצה לנטר את האוויר. יש למקם את צלחת הפטרי הרצויה במקום הייעודי לה בראש המכשיר ולהסיר את כיסוי הפלסטיק של הצלחת .
נלחץ על כפתור ההפעלה ונדליק את המכשיר. בעת ההדלקה יוצגו המספר הסידורי של הדוגם וגרסת התוכנה, ולאחר מכן התאריך והשעה, מצב ההפעלה, הספק שאיבת האוויר של המכשיר, ומצב הסוללה.
בשלב הבא ניתן לבחור נפח דיגום מאחד מ-17 נפחים שנקבעו על ידי היצרן או נפחים שנקבעו באופן ידני על ידי הלקוח (הטווח נע בין 30 ל-1,000 ליטרים). לאחר הבחירה בנפח הדיגום ניתן לבחור במספר אפשרויות: הפעלה מושהית של הדיגום/ מספר אינטרוולים/ זמן השהייה בין אינטרוולים/ מצב שאיבה (בדוגם הכפול)
המכשיר פועל במספר מצבי פעולה. במצב האוטומטי יש לאשר או להקליד את שם המשתמש ואת מקום הדגימה פעם אחת, ובמצב Secure (מאובטח) יש להקליד את שם המשתמש ואת מקום הדגימה כל פעם שמבוצעת פעולת דיגום חדשה. קיים גם מצב פעולה ידני.
בסוף הדגימה המכשיר ייתן חיווי על השלמת הפעולה ויישמע צפצוף, ניתן יהיה להעביר את הנתונים לתוכנה באמצעות כבל או בלוטות'.
לקבלת הצעת מחיר לרכישת דוגמי אוויר:
התקשרו אל אפרת לוריא 0547338326 או שלחו לנו